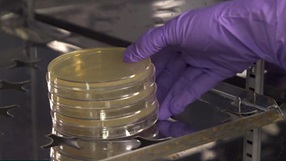
Sono Te O Toreba - Khám Phá Thế Giới Mãnh Liệt Của Cá Cược Thể Thao

Sono Te O Toreba là một khái niệm không xa lạ gì với những người đam mê thể thao, đặc biệt là trong lĩnh vực cá cược. Trong bài viết này, chúng ta sẽ cùng nhau khám phá những yếu tố quan trọng xung quanh Sono Te O Toreba, từ cách tính toán đến ảnh hưởng của nó đối với các quyết định cá cược.
Sono Te O Toreba và những yếu tố ảnh hưởng

Trong thế giới cá cược thể thao, Sono Te O Toreba đóng vai trò vô cùng quan trọng. Nó không chỉ đơn thuần là những con số mà còn ẩn chứa nhiều thông tin có giá trị. Để hiểu rõ hơn về Sono Te O Toreba, chúng ta cần xem xét những yếu tố ảnh hưởng đến nó.
Các loại Sono Te O Toreba cơ bản
Sono Te O Toreba được chia thành nhiều loại khác nhau, mỗi loại phục vụ cho mục đích và chiến lược cá cược riêng. Trong đó, tỷ lệ châu Á và tỷ lệ châu Âu là hai loại phổ biến nhất.
Tỷ lệ châu Á thường được sử dụng trong cá cược ở châu Á và mang lại nhiều lựa chọn cho người chơi. Nó cho phép người chơi tham gia vào nhiều hình thức cá cược khác nhau như đặt cược thắng thua, cược chấp hay cược tài xỉu.
Tỷ lệ châu Âu, ngược lại, thường được sử dụng tại các thị trường châu Âu. Nó dễ hiểu và đơn giản hơn rất nhiều, phù hợp cho những người mới bắt đầu tìm hiểu về cá cược.
Cách tính toán Sono Te O Toreba
Để có thể sử dụng Sono Te O Toreba một cách hiệu quả, người chơi cần nắm vững cách tính toán. Có nhiều phương pháp khác nhau để tính toán tỷ lệ dựa trên nhiều yếu tố như phong độ của đội bóng, lịch sử đối đầu và cả tình hình lực lượng.
Một trong những yếu tố quan trọng nhất trong việc tính toán tỷ lệ là phong độ hiện tại của đội bóng. Các trận đấu gần đây sẽ cung cấp cái nhìn tổng quan về khả năng thi đấu của đội. Lịch sử đối đầu cũng đóng vai trò không kém khi giúp người chơi dự đoán khả năng thắng của đội bóng trong những cuộc chạm trán trước đó.
Ảnh hưởng của đội hình và phong độ đến tỷ lệ
Đội hình và phong độ của các cầu thủ là một trong những yếu tố quyết định đến Sono Te O Toreba. Một đội bóng có sự ổn định trong đội hình sẽ có tỷ lệ cao hơn so với một đội bóng gặp vấn đề về lực lượng.
Ngoài ra, phong độ của đội bóng trong thời gian gần đây cũng rất quan trọng. Một đội bóng đang có chuỗi trận thắng liên tiếp sẽ được đánh giá cao hơn so với một đội bóng đang rơi vào khủng hoảng.
Chiến lược cá cược dựa trên Sono Te O Toreba
Để gia tăng khả năng chiến thắng, người chơi nên tận dụng các công cụ hỗ trợ cá cược. Những công cụ này sẽ giúp bạn đưa ra những quyết định thông minh hơn.
Phần mềm phân tích dữ liệu
Các phần mềm phân tích dữ liệu có thể cung cấp thông tin hữu ích về phong độ của đội bóng, lịch sử đối đầu và nhiều yếu tố khác. Chúng thường có giao diện thân thiện và dễ sử dụng, giúp người chơi nhanh chóng tìm kiếm thông tin cần thiết.
Việc sử dụng phần mềm này sẽ giúp giảm thiểu sai sót trong quá trình phân tích và đưa ra quyết định. Hơn nữa, một số phần mềm còn có tính năng dự đoán kết quả, giúp người chơi dự đoán chính xác hơn.
Trang web và diễn đàn cá cược
Tham gia vào các trang web và diễn đàn cá cược cũng là một cách hữu ích để cập nhật thông tin. Tại đây, người chơi có thể trao đổi kinh nghiệm, nhận định và học hỏi từ những người đã có kinh nghiệm trong lĩnh vực này.
Những thông tin từ cộng đồng cá cược có thể trở thành cơ sở quan trọng giúp người chơi đưa ra quyết định thông minh. Tuy nhiên, cần nhớ rằng không phải tất cả thông tin đều là chính xác, vì vậy nên kiểm chứng nguồn gốc.
Đọc sách và tài liệu chuyên sâu
Đọc sách và tài liệu chuyên sâu về cá cược cũng là một cách hiệu quả để nâng cao kiến thức. Nhiều cuốn sách cung cấp hướng dẫn chi tiết về cách cá cược, các chiến lược và cách quản lý vốn.
Việc đầu tư thời gian vào việc nghiên cứu sẽ giúp người chơi có cái nhìn sâu sắc hơn về Sono Te O Toreba và cách áp dụng nó trong thực tế. Điều này không chỉ giúp cải thiện khả năng thắng cược mà còn tạo nền tảng vững chắc cho những lần cá cược sau.
Các sai lầm thường gặp khi cá cược


Dù đã chuẩn bị kỹ lưỡng, người chơi vẫn có thể mắc phải những sai lầm nghiêm trọng. Dưới đây là một số sai lầm phổ biến mà người chơi cần lưu ý.
Thiếu kiên nhẫn và cảm tính
Một trong những sai lầm lớn nhất khi cá cược là thiếu kiên nhẫn. Nhiều người chơi thường nóng vội và đưa ra quyết định dựa trên cảm xúc thay vì phân tích thông tin một cách khoa học.
Cảm tính có thể khiến bạn đưa ra những quyết định sai lầm, dẫn đến thua lỗ. Hãy nhớ rằng cá cược là một trò chơi dài hạn, và đôi khi việc giữ bình tĩnh và chờ đợi cơ hội tốt là cần thiết.
Không quản lý vốn một cách hiệu quả
Quản lý vốn là chìa khóa để thành công trong cá cược. Nhiều người chơi thường không có kế hoạch chi tiết và dễ dàng tiêu hết số tiền mình có mà không thể quay trở lại.
Hãy xác định ngân sách cụ thể cho việc cá cược và tuân thủ nguyên tắc này. Việc quản lý vốn không chỉ giúp bạn tránh khỏi những tổn thất lớn mà còn cho phép bạn trải nghiệm cá cược lâu dài hơn.
Bỏ qua thông tin và phân tích
Nhiều người chơi thường bỏ qua bước phân tích thông tin và chỉ dựa vào may mắn. Điều này có thể dẫn đến những quyết định kém chất lượng và thua lỗ liên tiếp.
Hãy chăm sóc cho bản thân bằng việc nghiên cứu kỹ lưỡng trước khi đặt cược. Tìm kiếm thông tin từ nhiều nguồn khác nhau để đảm bảo rằng bạn có cái nhìn toàn diện về trận đấu.
Kết luận

Khi đã hiểu rõ về Sono Te O Toreba, người chơi cần xây dựng cho mình một chiến lược cá cược hợp lý. Dưới đây là một số chiến lược mà người chơi có thể áp dụng.
Phân tích sâu sắc trước khi đặt cược
Trước khi quyết định đặt cược, người chơi nên dành thời gian để phân tích tình hình. Điều này bao gồm việc xem xét phong độ của đội bóng, lực lượng cầu thủ và các yếu tố bên ngoài như thời tiết hay sân bãi.
Phân tích càng chi tiết, người chơi càng có cơ hội đưa ra quyết định chính xác. Ví dụ, nếu một đội bóng đang thiếu hụt lực lượng nhưng vẫn duy trì được phong độ tốt, tỷ lệ thắng cược sẽ có sự thay đổi đáng kể.
Sử dụng hệ thống cược thông minh
Người chơi có thể áp dụng các hệ thống cược khác nhau để tối ưu hóa lợi nhuận. Một trong những hệ thống phổ biến là Martingale, trong đó người chơi tăng tiền cược mỗi khi thua nhằm bù đắp lại khoản lỗ.
Tìm hiểu thêm
My Big Boss Daddy’sTuy nhiên, hệ thống này cũng có rủi ro nhất định. Người chơi cần có vốn đủ lớn để áp dụng và phải rất cẩn trọng để không rơi vào bẫy thua lỗ.
Theo dõi và điều chỉnh chiến lược
Thị trường cá cược luôn thay đổi, vì vậy người chơi cần theo dõi và điều chỉnh chiến lược của mình thường xuyên. Việc cập nhật thông tin mới nhất về phong độ của đội bóng và các yếu tố khác sẽ giúp người chơi đưa ra những quyết định đúng đắn hơn.
Nếu một chiến lược không mang lại kết quả như mong đợi, hãy sẵn sàng thay đổi. Điều này giúp bạn tránh được những khoản lỗ không cần thiết và nâng cao cơ hội thắng cược.
Các công cụ hỗ trợ cá cược hiệu quả







